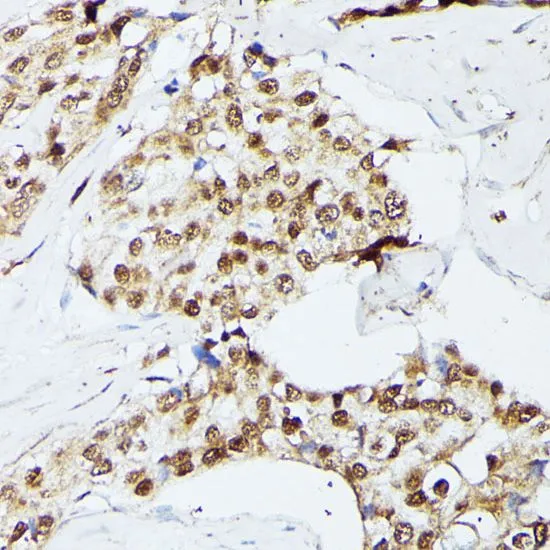

WB analysis of various sample lysates using GTX66353 KIF22 antibody. Dilution : 1:1000 Loading : 25microg per lane
KIF22 antibody
GTX66353
ApplicationsWestern Blot, ImmunoHistoChemistry, ImmunoHistoChemistry Paraffin
Product group Antibodies
TargetKIF22
Overview
- SupplierGeneTex
- Product NameKIF22 antibody
- Delivery Days Customer9
- Application Supplier NoteWB: 1:200 - 1:2000. IHC-P: 1:50 - 1:200. *Optimal dilutions/concentrations should be determined by the researcher.Not tested in other applications.
- ApplicationsWestern Blot, ImmunoHistoChemistry, ImmunoHistoChemistry Paraffin
- CertificationResearch Use Only
- ClonalityPolyclonal
- ConjugateUnconjugated
- Gene ID3835
- Target nameKIF22
- Target descriptionkinesin family member 22
- Target synonymsA-328A3.2, KID, KNSL4, OBP, OBP-1, OBP-2, SEMDJL2, kinesin-like protein KIF22, kinesin-like DNA-binding protein pseudogene, kinesin-like protein 4, oriP binding protein, origin of plasmid DNA replication-binding protein
- HostRabbit
- IsotypeIgG
- Protein IDQ14807
- Protein NameKinesin-like protein KIF22
- Scientific DescriptionThe protein encoded by this gene is a member of the kinesin-like protein family. The family members are microtubule-dependent molecular motors that transport organelles within cells and move chromosomes during cell division. The C-terminal half of this protein has been shown to bind DNA. Studies with the Xenopus homolog suggests its essential role in metaphase chromosome alignment and maintenance. Alternatively spliced transcript variants encoding different isoforms have been found for this gene. [provided by RefSeq, Jan 2012]
- Storage Instruction-20°C or -80°C,2°C to 8°C
- UNSPSC12352203

![ELISA analysis of antigen using GTX60506 KID antibody [5F3]. Red : Control antigen 100ng Purple : Antigen 10ng Green : Antigen 50ng Blue : Antigen 100ng](https://www.genetex.com/upload/website/prouct_img/normal/GTX60506/GTX60506_20170912_ELISA_w_23061123_875.webp)
![ELISA analysis of antigen using GTX60508 KID antibody [1E3]. Red : Control antigen 100ng Purple : Antigen 10ng Green : Antigen 50ng Blue : Antigen 100ng](https://www.genetex.com/upload/website/prouct_img/normal/GTX60508/GTX60508_20170912_ELISA_w_23061123_498.webp)